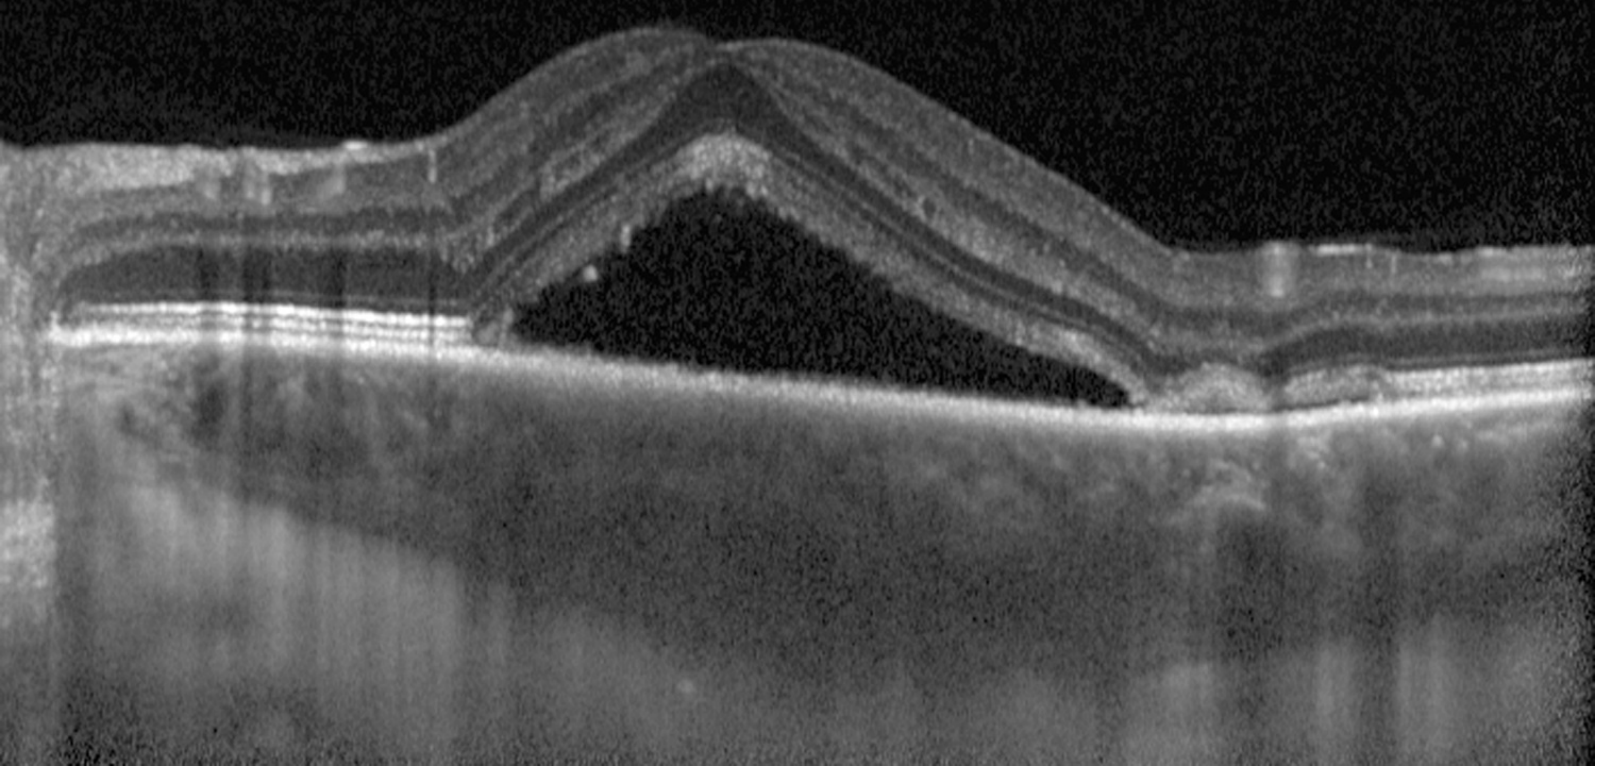

41 year male, systemic history not significant, diminution of vision in left eye since two weeks,painless. BCVA RE 6/6, LE 6/9. Anterior segment examination within normal range both eyes. Left eye shows elevation of macula . How to proceed with treatment?
Reading File
Finding Sources
Finding Sources
Finding Sources
Reading File
Reading File
Reading File
Reading File
Loading Image
Loading Image
Loading Image
This is a classic presentation of Central Serous Chorioretinopathy (CSCR) — a 41-year-old male with painless, unilateral diminution of vision (LE 6/9), normal anterior segment, and macular elevation (serous detachment of the neurosensory retina).
Diagnosis: Central Serous Chorioretinopathy (CSCR)
Key features matching this case:
- Young/middle-aged male (M:F ratio 3:1)
- Unilateral painless vision loss
- VA reduced to 6/9 (typical range 6/9–6/18; may improve with low-strength convex lens due to acquired hypermetropia from retinal elevation)
- Macular elevation = serous neurosensory detachment
- Clear anterior segment
Investigations to Confirm Diagnosis
Step-by-step workup:
-
Amsler grid testing — documents relative scotoma and metamorphopsia
-
Slit-lamp biomicroscopy (with 60D/90D/Hruby lens) — rule out concomitant choroidal neovascularization (CNV) and optic pit
-
Dilated fundus examination with indirect ophthalmoscopy — rule out choroidal tumour or rhegmatogenous retinal detachment (RRD)
-
OCT (Optical Coherence Tomography) — key investigation; demonstrates subretinal fluid, pigment epithelial detachments (PEDs), and choroidal thickening. Enhanced-depth imaging (EDI-OCT) shows choroidal thickening — a hallmark of pachychoroid diseaseEDI-OCT: subretinal fluid pooled under the elevated neurosensory retina with underlying choroidal thickening
-
IVFA (IV Fluorescein Angiography) — if diagnosis uncertain, CNV is suspected, or laser is being planned. Shows the nearly pathognomonic "smoke-stack" pattern of dye leakage (seen in 10–20% of cases)IVFA: classic smoke-stack pattern of dye leakage at the site of RPE breakdown

-
ICGA (Indocyanine Green Angiography) — shows choroidal hyperpermeability (multifocal hyperfluorescent patches in early phase); useful to identify subclinical foci
-
Fundus Autofluorescence (FAF) — shows decreased autofluorescence at leakage and old lesion sites
Differential Diagnoses to Exclude
| Condition | Differentiating Feature |
|---|---|
| AMD | Age ≥50, drusen, often bilateral |
| Optic pit | Pit visible at optic disc margin, contiguous detachment |
| Rhegmatogenous RD | Retinal break identifiable |
| Choroidal tumour (haemangioma/melanoma) | Choroidal mass on B-scan/clinical exam |
| Hypertensive retinopathy | BP elevated, A/V changes |
| PED | More distinct, sharply elevated RPE margin |
Treatment Plan
Since this is a 2-week acute presentation with reasonably preserved vision (6/9) and no systemic history, the approach is primarily observation with targeted intervention if needed.
1. Observation (First-line for Acute CSCR)
- Acute CSCR is self-limiting in ~80% of cases within 3–6 months with return to near-normal vision
- Observe and reassess every 6–8 weeks
- Worse prognosis if: recurrent disease, multiple detachment areas, prolonged course
2. Lifestyle & Causative Factor Modification
- Discontinue all corticosteroids (systemic, topical skin, nasal sprays) — this is the single most important modifiable factor
- Address psychological stress (type-A personality association)
- Screen for H. pylori, hypertension, sleep apnoea — treat if found
- In chronic cases: check serum cortisol and renal function
3. Pharmacological Options
| Agent | Indication | Regimen |
|---|---|---|
| Oral spironolactone | Acute CSCR to accelerate fluid resorption | 40 mg twice daily |
| Eplerenone | Chronic CSCR | Mineralocorticoid receptor antagonist; improves anatomic and visual outcomes |
| Anti-VEGF (intravitreal) | Only if CNV coexists | Bevacizumab alone not helpful without CNV |
4. Laser Treatment (If Indicated)
Indications for laser:
- Persistence of serous detachment for several months
- Recurrence in an eye with prior permanent visual deficit
- Fellow eye already affected with permanent deficit
- Occupational necessity requiring prompt vision restoration
Preferred modality: Subthreshold (micropulse) diode laser to the RPE leakage site — fewer adverse effects, significantly less retinal damage on OCT vs. conventional photocoagulation
⚠ Conventional laser photocoagulation may accelerate resolution but carries a risk of CNV formation — use low intensity only
5. Photodynamic Therapy (PDT)
- Half-dose verteporfin PDT (30–50% standard dose + 50% light intensity) — preferred for chronic CSCR or when rapid resolution is needed
- Leads to complete resolution including severe chronic cases
- Lower incidence of choroidal ischaemia vs. full-dose regimens
- Can be combined with intravitreal anti-VEGF when CNV coexists
Summary Algorithm for This Patient
Acute CSCR (2 weeks) → Confirm with OCT + IVFA
↓
Observe for 3 months + stop all steroids
↓
Resolution? → Follow-up 6–8 weekly
↓ (if no resolution by 3–4 months)
Spironolactone 40 mg BD ± Micropulse laser / Half-dose PDT
↓ (if CNV develops)
Intravitreal Anti-VEGF
Key clinical tip: All forms of corticosteroid treatment must be discontinued if possible in patients with chronic or recurrent CSCR. — Kanski's Clinical Ophthalmology, 10th ed., p. 620
Sources: Kanski's Clinical Ophthalmology 10th Ed., p. 617–620; Wills Eye Manual, p. 827–831
What is the role of eplinorone in CSCR new patient?
Finding Sources
Finding Sources
Finding Sources
The textbooks don't have a dedicated entry on eplerenone in CSCR beyond the brief mention already retrieved. Here is a consolidated answer drawing from the retrieved textbook content and pharmacological knowledge:
Eplerenone in CSCR — Role in a New Patient
Mechanism of Action
CSCR is strongly linked to elevated mineralocorticoid receptor (MR) activity — either from exogenous corticosteroids or endogenous hypercortisolism. Mineralocorticoid receptors are expressed in the choroidal vasculature and RPE. Their excess activation leads to:
- Choroidal vascular hyperpermeability
- RPE pump dysfunction
- Subretinal fluid accumulation
Eplerenone is a selective mineralocorticoid receptor antagonist (MRA) — it blocks aldosterone and cortisol binding at MR, thereby reducing choroidal hyperpermeability and facilitating subretinal fluid resorption.
Evidence in Acute (New) CSCR
This is where it gets nuanced:
| Setting | Evidence for Eplerenone |
|---|---|
| Chronic CSCR (>4 months) | Good evidence — improves anatomic and visual outcomes (Wills Eye Manual, p. 831; Kanski 10th ed.) |
| Acute CSCR (<3–4 months, new patient) | Limited / not first-line — the textbook evidence supports spironolactone (not eplerenone) for acute cases |
From Kanski's Clinical Ophthalmology 10th ed., p. 620:
"Oral spironolactone (40 mg twice daily) may result in faster resorption of subretinal fluid than no treatment in acute CSR."
From Wills Eye Manual, p. 831:
"Eplerenone and spironolactone have been associated with improved anatomic and visual outcomes in chronic CSCR."
Practical Role in a New (Acute) Patient
For a new presentation like your patient (2 weeks, acute):
- Eplerenone is not a first-line agent in the acute phase
- Observation for 3 months remains the standard initial approach, as ~80% resolve spontaneously
- If you wish to use an MRA in the acute phase, spironolactone 40 mg BD has more supporting evidence for accelerating fluid resolution
- Eplerenone 25–50 mg once daily may be preferred over spironolactone in male patients due to spironolactone's anti-androgenic side effects (gynaecomastia, decreased libido), making it a reasonable alternative when MRA therapy is initiated
- Eplerenone becomes more relevant if the case transitions to chronic CSCR (>3–4 months without resolution)
Eplerenone vs. Spironolactone in CSCR
| Feature | Eplerenone | Spironolactone |
|---|---|---|
| Selectivity | Highly selective MRA | Non-selective (also blocks androgen/progesterone receptors) |
| Anti-androgenic side effects | Minimal | Gynaecomastia, sexual dysfunction in males |
| Evidence in acute CSCR | Limited | Stronger (faster SRF resorption) |
| Evidence in chronic CSCR | Good | Good |
| Preferred in | Male patients (tolerability), chronic CSCR | Acute CSCR when pharmacotherapy chosen |
Bottom Line for Your Patient
In this 41-year-old male with 2 weeks of acute CSCR:
- Observe first — most cases resolve spontaneously within 3–6 months
- Discontinue steroids if any exposure is identified
- If treatment is needed (occupational urgency, patient preference, or no improvement by 6–8 weeks), spironolactone 40 mg BD is the better-evidenced acute-phase MRA
- Eplerenone is a suitable alternative (especially given tolerability in males) and becomes the preferred MRA if the case becomes chronic
Sources: Kanski's Clinical Ophthalmology 10th Ed., p. 620; Wills Eye Manual, p. 831
This is a shared conversation. Sign in to Orris to start your own chat.